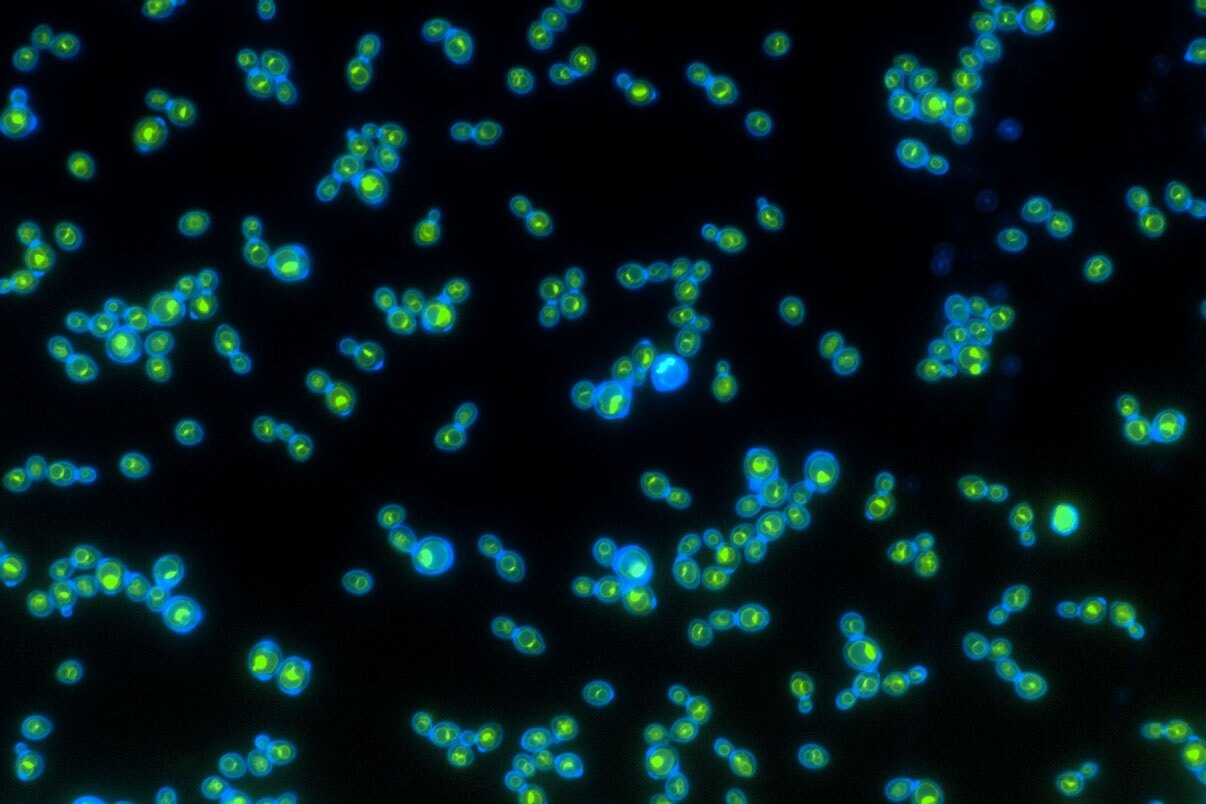

Модифицированные дрожжи питаются светом вместо сахара
Исследователи из Технологического института Джорджии создали вид дрожжей, который использует в качестве источника энергии, не сахар, а свет. Такие дрожжи больше похожи на растения или фотосинтезирующие бактерии.
Сделан очень важный шаг для создания искусственного фотосинтеза.
Дрожжи любят углеводы. Они живут за счет ферментации сахаров и крахмала, например, в винограде или тесте. А в результате мы едим мягкий хлеб и пьем вино. Исследователи из Технологического института Джорджии создали вид дрожжей, который использует в качестве источника энергии, не сахар, а свет. Такие дрожжи больше похожи на растения. Ведь растения с помощью фотосинтеза умеют напрямую использовать свет для создания углеводов.
Для преобразования углекислого газа в сахара, которые служат топливом для жизни на Земле, растения полагаются на белковый комплекс, включающий хлорофилл. Это комплекс используется для переноса электронов и протонов, которые осуществляют химические реакции и передают энергию. Исследователи многих стран уже много лет работают над воссозданием фотосинтеза, например, чтобы использовать свет в качестве источника энергии для солнечных батарей.